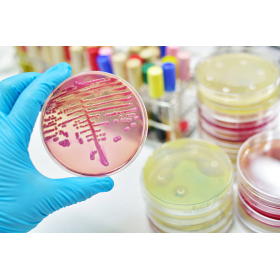
Base de gélose Palcam pour Listeria (500g)

Base de gélose Palcam pour Listeria (500g)
La Base de gélose Palcam pour Listeria permet de préparer un milieu pour l'isolement et la détection des Listeria monocytogenes et d'autres Listeria spp.
 Groupez vos commandes
Groupez vos commandes
Complétez votre panier en parcourant nos 5000 produits, et optimisez vos frais de port.
 Validez votre panier maintenant et payez plus tard
Validez votre panier maintenant et payez plus tard
Nous offrons la possibilité de valider votre panier contre émission d'une facture.
Vous aimerez aussi
-
LISTERIA PALCAM supplément...
74,55 €